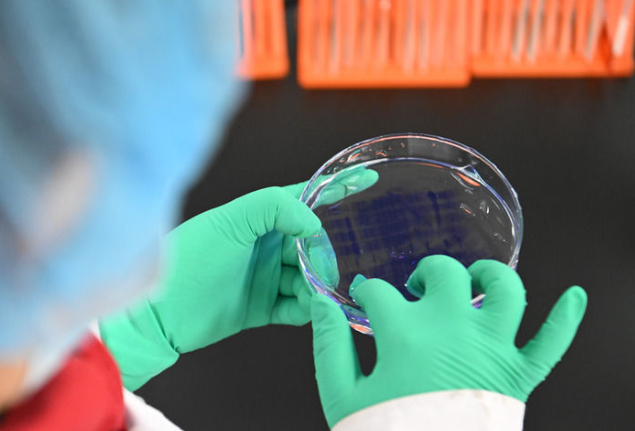

一切偉大成就都是接續(xù)奮斗的結(jié)果,一切偉大事業(yè)都需要在繼往開(kāi)來(lái)中推進(jìn)。
“十四五”即將圓滿收官、“十五五”正待開(kāi)啟序幕之際,中央經(jīng)濟(jì)工作會(huì)議12月10日至11日在北京舉行。
習(xí)近平總書(shū)記在會(huì)上發(fā)表重要講話,總結(jié)2025年經(jīng)濟(jì)工作,分析當(dāng)前經(jīng)濟(jì)形勢(shì),部署2026年經(jīng)濟(jì)工作,駕馭中國(guó)經(jīng)濟(jì)航船破浪前行。
錨定“十五五”時(shí)期經(jīng)濟(jì)社會(huì)發(fā)展主要目標(biāo),確?!笆逦濉遍_(kāi)好局、起好步,以習(xí)近平同志為核心的黨中央團(tuán)結(jié)帶領(lǐng)全黨全國(guó)各族人民迎難而上、勇往直前,奮力書(shū)寫(xiě)中國(guó)經(jīng)濟(jì)的嶄新篇章。

信心與定力:“我國(guó)經(jīng)濟(jì)頂壓前行、向新向優(yōu)發(fā)展”
2025年,中國(guó)式現(xiàn)代化進(jìn)程中具有重要意義的一年。
今年以來(lái),國(guó)際環(huán)境變亂交織,我國(guó)發(fā)展經(jīng)歷轉(zhuǎn)型調(diào)整的挑戰(zhàn),經(jīng)濟(jì)穩(wěn)定運(yùn)行壓力有所上升。
面對(duì)國(guó)內(nèi)外形勢(shì)深刻復(fù)雜的變化,全黨全國(guó)勠力同心、奮力拼搏,堅(jiān)定不移貫徹新發(fā)展理念、推動(dòng)高質(zhì)量發(fā)展,經(jīng)濟(jì)社會(huì)發(fā)展主要目標(biāo)將順利完成。
“我國(guó)經(jīng)濟(jì)頂壓前行、向新向優(yōu)發(fā)展,展現(xiàn)強(qiáng)大韌性和活力。”10日第一次全體會(huì)議上,習(xí)近平總書(shū)記對(duì)今年經(jīng)濟(jì)工作作出全面總結(jié)。
這是一份難能可貴、成色十足的成績(jī)單——
運(yùn)行總體平穩(wěn),穩(wěn)中有進(jìn),預(yù)計(jì)全年經(jīng)濟(jì)總量將達(dá)到140萬(wàn)億元左右,就業(yè)總體穩(wěn)定,外貿(mào)較快增長(zhǎng),出口多元化成效明顯;
現(xiàn)代化產(chǎn)業(yè)體系建設(shè)持續(xù)推進(jìn),新質(zhì)生產(chǎn)力穩(wěn)步發(fā)展,科技創(chuàng)新成果豐碩,人工智能、生物醫(yī)藥、機(jī)器人等研發(fā)應(yīng)用走在世界前列;
2025年2月20日,在位于京津中關(guān)村科技城的中科拜克(天津)生物藥業(yè)有限公司,實(shí)驗(yàn)人員在檢驗(yàn)生物制品蛋白分子量。新華社記者 孫凡越 攝
改革開(kāi)放邁出新步伐,全國(guó)統(tǒng)一大市場(chǎng)建設(shè)向縱深推進(jìn),綜合整治“內(nèi)卷式”競(jìng)爭(zhēng)成效顯現(xiàn),自主開(kāi)放有序推進(jìn);
重點(diǎn)領(lǐng)域風(fēng)險(xiǎn)化解取得積極進(jìn)展,地方政府隱性債務(wù)有序置換,中小金融機(jī)構(gòu)改革化險(xiǎn)成效明顯,守住了不發(fā)生系統(tǒng)性風(fēng)險(xiǎn)的底線;
民生保障更加有力,育兒補(bǔ)貼、學(xué)前一年免費(fèi)教育等政策相繼實(shí)施,社會(huì)保障水平持續(xù)提高,社會(huì)大局保持穩(wěn)定……

2025年2月20日,在山東省日照市東港區(qū)知子樹(shù)托幼園,老師陪伴孩子做游戲。新華社記者 郭緒雷 攝
走過(guò)風(fēng)雨洗禮、劈波斬浪的2025年,更顯“十四五”時(shí)期我國(guó)發(fā)展歷程的極不尋常、極不平凡。
習(xí)近平總書(shū)記細(xì)數(shù)過(guò)去5年我國(guó)發(fā)展的一個(gè)個(gè)突出亮點(diǎn):“科技創(chuàng)新成果令世界刮目相看”“越來(lái)越多品牌蜚聲海外”“APEC藍(lán)成為常態(tài)”“平安中國(guó)成為靚麗的國(guó)家名片”……
“我們有效應(yīng)對(duì)各種沖擊挑戰(zhàn),推動(dòng)黨和國(guó)家事業(yè)取得新的重大成就,第二個(gè)百年奮斗目標(biāo)新征程實(shí)現(xiàn)良好開(kāi)局?!绷?xí)近平總書(shū)記對(duì)“十四五”時(shí)期發(fā)展作出高度評(píng)價(jià)。
這是信心與共識(shí)的凝聚。
10日下午開(kāi)始,與會(huì)同志進(jìn)行分組討論,談?wù)J識(shí)、講體會(huì)、提建議。
大家一致表示,這些重大成就的取得,根本在于以習(xí)近平同志為核心的黨中央領(lǐng)航掌舵,在于習(xí)近平新時(shí)代中國(guó)特色社會(huì)主義思想特別是習(xí)近平經(jīng)濟(jì)思想科學(xué)指引。
登高望遠(yuǎn),撥云見(jiàn)日。
會(huì)議著眼全局,從外部環(huán)境變化影響加深、國(guó)內(nèi)供強(qiáng)需弱矛盾突出、重點(diǎn)領(lǐng)域風(fēng)險(xiǎn)隱患較多等方面,深入分析我國(guó)發(fā)展面臨的老問(wèn)題與新挑戰(zhàn)。
“這些大多是發(fā)展中、轉(zhuǎn)型中的問(wèn)題,繞不開(kāi)、躲不過(guò),但經(jīng)過(guò)努力是可以解決的?!绷?xí)近平總書(shū)記堅(jiān)定指出,總體上看,我國(guó)經(jīng)濟(jì)長(zhǎng)期向好的支撐條件和基本趨勢(shì)沒(méi)有改變。我們要堅(jiān)定信心、用好優(yōu)勢(shì)、應(yīng)對(duì)挑戰(zhàn),不斷鞏固拓展經(jīng)濟(jì)穩(wěn)中向好勢(shì)頭。
清醒的判斷,源自對(duì)時(shí)代脈搏的準(zhǔn)確把握。
在以往中央經(jīng)濟(jì)工作會(huì)議基礎(chǔ)上,這次會(huì)議進(jìn)一步總結(jié)我們黨對(duì)經(jīng)濟(jì)工作的規(guī)律性認(rèn)識(shí)。
習(xí)近平總書(shū)記以“五個(gè)必須”概括做好新形勢(shì)下經(jīng)濟(jì)工作新的認(rèn)識(shí)和體會(huì)——
“必須充分挖掘經(jīng)濟(jì)潛能”,強(qiáng)調(diào)要進(jìn)一步用好我國(guó)產(chǎn)業(yè)體系完整、市場(chǎng)規(guī)模巨大、人才資源豐富等優(yōu)勢(shì);
“必須堅(jiān)持政策支持和改革創(chuàng)新并舉”,強(qiáng)調(diào)既要加大宏觀政策逆周期調(diào)節(jié)力度,又要不失時(shí)機(jī)深化改革,激發(fā)創(chuàng)新活力;
“必須做到既‘放得活’又‘管得好’”,強(qiáng)調(diào)“放”的目的是破除影響生產(chǎn)力發(fā)展的體制機(jī)制障礙,“管”的本質(zhì)要求是建設(shè)法治經(jīng)濟(jì);
“必須堅(jiān)持投資于物和投資于人緊密結(jié)合”,強(qiáng)調(diào)既要擴(kuò)大對(duì)實(shí)體經(jīng)濟(jì)和科技創(chuàng)新的有效投資,又要加強(qiáng)人力資源開(kāi)發(fā);
“必須以苦練內(nèi)功來(lái)應(yīng)對(duì)外部挑戰(zhàn)”,強(qiáng)調(diào)面對(duì)國(guó)際風(fēng)云變幻和各種風(fēng)險(xiǎn)挑戰(zhàn),要保持戰(zhàn)略定力,堅(jiān)定不移把自己的事情辦好。
與會(huì)同志認(rèn)為,“五個(gè)必須”是實(shí)現(xiàn)高質(zhì)量發(fā)展、推進(jìn)中國(guó)式現(xiàn)代化的科學(xué)方法論,進(jìn)一步豐富和發(fā)展了習(xí)近平經(jīng)濟(jì)思想,為做好經(jīng)濟(jì)工作提供了新的重要遵循。
乘風(fēng)破浪,揚(yáng)帆遠(yuǎn)航。
習(xí)近平總書(shū)記的重要講話激發(fā)起強(qiáng)烈共鳴和強(qiáng)大信心:“力求在擴(kuò)大消費(fèi)和投資、發(fā)展科技和產(chǎn)業(yè)、促進(jìn)城鄉(xiāng)融合和區(qū)域協(xié)調(diào)發(fā)展等方面培育形成更多新的增長(zhǎng)點(diǎn)”“調(diào)動(dòng)地方和企業(yè)積極性,推動(dòng)經(jīng)濟(jì)更多轉(zhuǎn)向內(nèi)生增長(zhǎng)”“不斷做強(qiáng)做優(yōu)做大實(shí)體經(jīng)濟(jì),全面增強(qiáng)自主創(chuàng)新能力”。

方向與路徑:“穩(wěn)中求進(jìn)、提質(zhì)增效”
2026年是“十五五”開(kāi)局之年,中國(guó)經(jīng)濟(jì)航船迎來(lái)新的出發(fā)。
逐夢(mèng)未來(lái)的新航程,有開(kāi)闊水域,也有激流險(xiǎn)灘——
放眼全球,百年變局加速演進(jìn),國(guó)際力量對(duì)比深刻調(diào)整,新一輪科技革命和產(chǎn)業(yè)變革加速突破。同時(shí),單邊主義、保護(hù)主義抬頭,國(guó)際經(jīng)貿(mào)秩序遇到嚴(yán)峻挑戰(zhàn),大國(guó)博弈更趨激烈。
環(huán)顧國(guó)內(nèi),把握發(fā)展的重要戰(zhàn)略機(jī)遇期,我國(guó)正堅(jiān)定不移以高質(zhì)量發(fā)展推進(jìn)中國(guó)式現(xiàn)代化,但發(fā)展不平衡不充分問(wèn)題仍然突出。
變局蘊(yùn)含機(jī)遇,挑戰(zhàn)激發(fā)斗志。
“完整準(zhǔn)確全面貫徹新發(fā)展理念,加快構(gòu)建新發(fā)展格局,著力推動(dòng)高質(zhì)量發(fā)展”;
“更好統(tǒng)籌國(guó)內(nèi)經(jīng)濟(jì)工作和國(guó)際經(jīng)貿(mào)斗爭(zhēng),更好統(tǒng)籌發(fā)展和安全”;
“推動(dòng)經(jīng)濟(jì)實(shí)現(xiàn)質(zhì)的有效提升和量的合理增長(zhǎng),保持社會(huì)和諧穩(wěn)定”;
…………
習(xí)近平總書(shū)記高瞻遠(yuǎn)矚、深謀遠(yuǎn)慮,為做好開(kāi)局之年經(jīng)濟(jì)工作指明方向。
“穩(wěn)中求進(jìn)、提質(zhì)增效”,這8個(gè)字指明2026年經(jīng)濟(jì)工作的政策取向。
穩(wěn)中求進(jìn)工作總基調(diào),是我們黨治國(guó)理政的重要原則,是“十五五”時(shí)期仍需一以貫之的重要方法論。
統(tǒng)籌“穩(wěn)”與“進(jìn)”,要精準(zhǔn)施策,增強(qiáng)宏觀政策前瞻性針對(duì)性協(xié)同性。
——繼續(xù)實(shí)施更加積極的財(cái)政政策。保持必要的財(cái)政赤字、債務(wù)總規(guī)模和支出總量。
——繼續(xù)實(shí)施適度寬松的貨幣政策。引導(dǎo)金融機(jī)構(gòu)加力支持?jǐn)U大內(nèi)需、科技創(chuàng)新、中小微企業(yè)等重點(diǎn)領(lǐng)域。
——增強(qiáng)宏觀政策取向一致性和有效性。將各類經(jīng)濟(jì)政策和非經(jīng)濟(jì)政策、存量政策和增量政策納入宏觀政策取向一致性評(píng)估。
會(huì)議在宏觀政策部署上,以繼續(xù)實(shí)施“更加積極有為的宏觀政策”的穩(wěn)定信號(hào),夯實(shí)經(jīng)濟(jì)大盤的穩(wěn)定底座,加快推動(dòng)經(jīng)濟(jì)發(fā)展從量到質(zhì)的轉(zhuǎn)變。
一位與會(huì)同志深有感觸地說(shuō),明年政策取向在“穩(wěn)”和“進(jìn)”的基礎(chǔ)上,強(qiáng)調(diào)“質(zhì)”和“效”,既釋放宏觀政策“穩(wěn)”的信號(hào),又順應(yīng)“十五五”開(kāi)局指明優(yōu)化方向,彰顯復(fù)雜變局下黨中央對(duì)時(shí)與勢(shì)的準(zhǔn)確把握。
提升“質(zhì)”與“效”,要錨定目標(biāo),在堅(jiān)持高質(zhì)量發(fā)展中贏得主動(dòng)。
在一個(gè)更加不穩(wěn)定不確定的世界中謀求發(fā)展,唯有走好自己的路,才能“亂云飛渡仍從容”,在變局中勇開(kāi)新局。
會(huì)議以“八個(gè)堅(jiān)持”部署明年經(jīng)濟(jì)工作重點(diǎn)任務(wù),“堅(jiān)持內(nèi)需主導(dǎo),建設(shè)強(qiáng)大國(guó)內(nèi)市場(chǎng)”擺在首位。
大國(guó)經(jīng)濟(jì),一個(gè)重要特征是內(nèi)部可循環(huán)。
擴(kuò)大內(nèi)需,不僅是抵御外部沖擊、推動(dòng)我國(guó)經(jīng)濟(jì)穩(wěn)中向好的有效途徑,更是推動(dòng)高質(zhì)量發(fā)展、構(gòu)建新發(fā)展格局的戰(zhàn)略之舉。

2025年8月27日在浙江省湖州市長(zhǎng)興縣虹星橋鎮(zhèn)宋高村稻香伴日營(yíng)地內(nèi)拍攝的咖啡屋。這是宋高村做優(yōu)全域土地整治后的農(nóng)文旅新嘗試,集餐飲、旅游、農(nóng)業(yè)和文化于一體。新華社記者 徐昱 攝
“深入實(shí)施提振消費(fèi)專項(xiàng)行動(dòng),制定實(shí)施城鄉(xiāng)居民增收計(jì)劃”“清理消費(fèi)領(lǐng)域不合理限制措施,釋放文旅、賽事、餐飲、康養(yǎng)等服務(wù)消費(fèi)潛力,同時(shí)要加強(qiáng)監(jiān)管、規(guī)范秩序”“著眼惠民生增后勁,推動(dòng)投資止跌回穩(wěn),城市更新是投資重要領(lǐng)域”……
習(xí)近平總書(shū)記作出的一系列重要部署,強(qiáng)調(diào)從供需兩側(cè)發(fā)力,突出在發(fā)展中補(bǔ)齊民生短板。
抓住關(guān)鍵,綱舉目張。
“十五五”規(guī)劃建議中,“建設(shè)現(xiàn)代化產(chǎn)業(yè)體系,鞏固壯大實(shí)體經(jīng)濟(jì)根基”“加快高水平科技自立自強(qiáng),引領(lǐng)發(fā)展新質(zhì)生產(chǎn)力”位列12項(xiàng)戰(zhàn)略任務(wù)前兩位。
在應(yīng)對(duì)變局中辦好自己的事,堅(jiān)持創(chuàng)新是破局關(guān)鍵。
這次會(huì)議上,習(xí)近平總書(shū)記圍繞“堅(jiān)持創(chuàng)新驅(qū)動(dòng),加緊培育壯大新動(dòng)能”作出新的重大部署。
建設(shè)具有全球影響力的國(guó)際科技創(chuàng)新中心是習(xí)近平總書(shū)記親自謀劃、部署推動(dòng)的一項(xiàng)重大戰(zhàn)略任務(wù)。
這次會(huì)議提出,建設(shè)北京(京津冀)、上海(長(zhǎng)三角)、粵港澳大灣區(qū)國(guó)際科技創(chuàng)新中心。

2025年4月26日,在安徽省合肥市,觀眾在第三屆中國(guó)(安徽)科技創(chuàng)新成果轉(zhuǎn)化交易會(huì)上參觀一款數(shù)據(jù)驅(qū)動(dòng)的全流程機(jī)器化學(xué)家。新華社記者 周牧 攝
“黨中央決定,將北京國(guó)際科創(chuàng)中心擴(kuò)圍至京津冀,上海國(guó)際科創(chuàng)中心擴(kuò)圍至長(zhǎng)三角,目的是加快形成我國(guó)原始創(chuàng)新的主要策源地,共同打造科技強(qiáng)國(guó)建設(shè)的戰(zhàn)略指引,樹(shù)立以科技支撐引領(lǐng)中國(guó)式現(xiàn)代化的標(biāo)桿?!绷?xí)近平總書(shū)記闡明其中的深遠(yuǎn)考量。

這是2025年12月11日拍攝的位于廣州市南沙區(qū)明珠灣靈山島尖的大灣區(qū)科學(xué)會(huì)堂(無(wú)人機(jī)照片)。新華社記者 鄧華 攝
事業(yè)發(fā)展,要在創(chuàng)新;創(chuàng)新之道,唯在得人。
“制定一體推進(jìn)教育科技人才發(fā)展方案”,這一新舉措引起不少與會(huì)同志的關(guān)注。
“教育是基礎(chǔ),科技是關(guān)鍵,人才是根本,三者協(xié)同融合發(fā)展體現(xiàn)投資于物和投資于人的緊密結(jié)合,是高質(zhì)量發(fā)展的迫切需要,也是應(yīng)對(duì)國(guó)際競(jìng)爭(zhēng)的必然要求?!狈纸M討論中,與會(huì)同志形成共識(shí)。
戰(zhàn)略上更加主動(dòng),戰(zhàn)術(shù)上更加精準(zhǔn)。
堅(jiān)持改革攻堅(jiān),增強(qiáng)高質(zhì)量發(fā)展動(dòng)力活力;堅(jiān)持對(duì)外開(kāi)放,推動(dòng)多領(lǐng)域合作共贏;堅(jiān)持協(xié)調(diào)發(fā)展,促進(jìn)城鄉(xiāng)融合和區(qū)域聯(lián)動(dòng);堅(jiān)持“雙碳”引領(lǐng),推動(dòng)全面綠色轉(zhuǎn)型;堅(jiān)持民生為大,努力為人民群眾多辦實(shí)事;堅(jiān)持守牢底線,積極穩(wěn)妥化解重點(diǎn)領(lǐng)域風(fēng)險(xiǎn)。
制定全國(guó)統(tǒng)一大市場(chǎng)建設(shè)條例;深化外商投資促進(jìn)體制機(jī)制改革;加強(qiáng)重點(diǎn)城市群協(xié)調(diào)聯(lián)動(dòng),深化跨行政區(qū)合作;制定能源強(qiáng)國(guó)建設(shè)規(guī)劃綱要;實(shí)施穩(wěn)崗擴(kuò)容提質(zhì)行動(dòng);著力穩(wěn)定房地產(chǎn)市場(chǎng)……圍繞“八個(gè)堅(jiān)持”,會(huì)議提出一系列新部署新舉措。
與會(huì)同志一致認(rèn)為,這“八個(gè)堅(jiān)持”突出短期經(jīng)濟(jì)工作與中長(zhǎng)期高質(zhì)量發(fā)展目標(biāo)相結(jié)合,既是對(duì)“十四五”時(shí)期成功經(jīng)驗(yàn)的有效總結(jié),也為“十五五”開(kāi)局之年指明方向,確保中國(guó)經(jīng)濟(jì)在“穩(wěn)中求進(jìn)、提質(zhì)增效”軌道上行穩(wěn)致遠(yuǎn)。

團(tuán)結(jié)與實(shí)干:“確?!逦濉_(kāi)好局、起好步”
形勢(shì)越是復(fù)雜,越要加強(qiáng)黨的領(lǐng)導(dǎo),形成統(tǒng)一意志。
這次會(huì)議明確了黨中央關(guān)于明年經(jīng)濟(jì)工作的思路、任務(wù)、政策,在實(shí)際工作中落地落實(shí)落細(xì)至關(guān)重要。
習(xí)近平總書(shū)記指出:“定了就要落實(shí),各級(jí)各部門都要有大局觀、執(zhí)行力?!?/p>
抓落實(shí),總書(shū)記曾多次強(qiáng)調(diào)因地制宜。
這次會(huì)議上,習(xí)近平總書(shū)記圍繞發(fā)展新質(zhì)生產(chǎn)力、生態(tài)環(huán)保、農(nóng)村改廁等,進(jìn)一步闡明因地制宜的重要性。
“因地制宜,本質(zhì)就是實(shí)事求是?!笨倳?shū)記強(qiáng)調(diào),落實(shí)中需要結(jié)合實(shí)際、因地制宜,但不能自行其是、搞本位主義。
抓落實(shí),要樹(shù)立和踐行正確政績(jī)觀。
會(huì)議強(qiáng)調(diào),要堅(jiān)持為人民出政績(jī)、以實(shí)干出政績(jī),自覺(jué)按規(guī)律辦事,完善差異化考核評(píng)價(jià)體系。
求真務(wù)實(shí),擔(dān)當(dāng)作為。與會(huì)同志表示,要自覺(jué)把思想和行動(dòng)統(tǒng)一到黨中央對(duì)形勢(shì)的科學(xué)判斷上來(lái),按照黨中央決策部署和習(xí)近平總書(shū)記重要講話要求,增強(qiáng)責(zé)任感和使命感,切實(shí)提高應(yīng)對(duì)復(fù)雜形勢(shì)、處理復(fù)雜問(wèn)題的能力,確保上下貫通、執(zhí)行有力。
政策預(yù)期穩(wěn),經(jīng)濟(jì)大盤才能穩(wěn)。
會(huì)議指出,要全面貫徹明年經(jīng)濟(jì)工作的總體要求和政策取向,堅(jiān)持積極務(wù)實(shí)的目標(biāo)導(dǎo)向,著力解決存在的困難問(wèn)題,在質(zhì)的有效提升上取得更大突破,增強(qiáng)居民和企業(yè)的獲得感;增強(qiáng)改革與政策的協(xié)同效應(yīng),推動(dòng)經(jīng)濟(jì)運(yùn)行和市場(chǎng)預(yù)期持續(xù)向好。

2025年6月18日,河北省唐山市蘆臺(tái)經(jīng)濟(jì)開(kāi)發(fā)區(qū)一家采暖設(shè)備企業(yè)的工人在生產(chǎn)線上工作。新華社記者 楊世堯 攝
經(jīng)濟(jì)工作要取得實(shí)效,必須把握關(guān)鍵著力點(diǎn)。
會(huì)議明確,圍繞做強(qiáng)國(guó)內(nèi)大循環(huán),拓展內(nèi)需增長(zhǎng)新空間;圍繞發(fā)展新質(zhì)生產(chǎn)力,推動(dòng)科技創(chuàng)新和產(chǎn)業(yè)創(chuàng)新深度融合;圍繞激發(fā)高質(zhì)量發(fā)展的動(dòng)力活力,堅(jiān)定不移深化改革擴(kuò)大開(kāi)放;圍繞不斷增進(jìn)民生福祉,加大保障和改善民生力度;圍繞守牢安全底線,穩(wěn)妥做好重點(diǎn)領(lǐng)域風(fēng)險(xiǎn)化解。

2025年11月30日,顧客在海南三亞國(guó)際免稅城購(gòu)物。新華社記者 郭程 攝
當(dāng)前,各地區(qū)各部門各方面正在按照黨的二十屆四中全會(huì)《建議》,編制國(guó)家和地方“十五五”規(guī)劃及專項(xiàng)規(guī)劃。
對(duì)此,習(xí)近平總書(shū)記明確要求:“要加強(qiáng)統(tǒng)籌,精簡(jiǎn)優(yōu)化交叉重復(fù)、缺乏實(shí)效的規(guī)劃編制任務(wù),防止規(guī)劃過(guò)多過(guò)濫。所有規(guī)劃都要實(shí)事求是,追求實(shí)實(shí)在在、沒(méi)有水分的增長(zhǎng),推動(dòng)高質(zhì)量、可持續(xù)的發(fā)展?!?/p>
未來(lái)5年,是基本實(shí)現(xiàn)社會(huì)主義現(xiàn)代化夯實(shí)基礎(chǔ)、全面發(fā)力的關(guān)鍵時(shí)期,良好的開(kāi)局是成功的一半。
擊鼓催征,時(shí)不我待。
習(xí)近平總書(shū)記發(fā)出有力號(hào)召:“全黨全社會(huì)要更加緊密團(tuán)結(jié)在黨中央周圍,萬(wàn)眾一心、砥礪前行,奮力實(shí)現(xiàn)明年經(jīng)濟(jì)社會(huì)發(fā)展目標(biāo)任務(wù),確?!逦濉_(kāi)好局、起好步?!?/p>

文字記者:趙超、韓潔
海報(bào)設(shè)計(jì):代云鶴